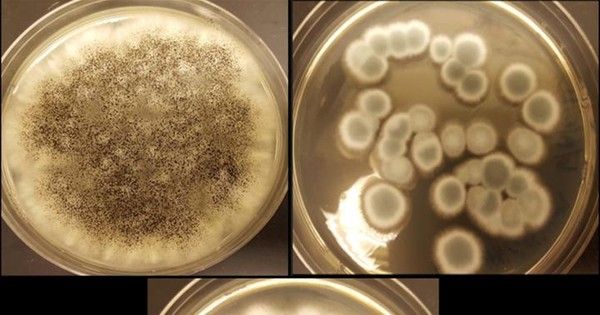

Batterie ricaricabili al litio riciclate grazie ai funghi. È lo studio presentato durante l’annuale meeting del American Chemical Society che propone una soluzione per riciclare le batterie più utilizzate oggi sui dispositivi mobili quali smartphone e tablet, ma non solo.
Le batterie ricaricabili non sono eterne, arriva un punto della loro vita in cui le ricariche non sono più efficaci. La chimica alla base delle batterie esaurisce le reazioni che le consentono di sopravvivere, cosa succede quando queste non funzionano più? Vanno buttate e sostituite. Le batterie usate spesso finiscono nelle discariche o negli inceneritori, procurando un danno all’ambiente.
La ricerca. Un team di ricercatori dell’Università della Florida del Sud hanno presentato la loro ricerca 252° Meeting del American Chemical Society (ACS). “L’idea è venuta la prima volta da uno studente che ha avuto esperienza di estrazione di alcuni metalli da scorie di rifiuti lasciati dalle operazioni di fusione“, afferma Jeffrey A. Cunningham, Ph.D., team leader del progetto. “Vedendo l’enorme crescita negli smartphone e in tutti gli altri prodotti con batterie ricaricabili, abbiamo deciso di spostare la nostra attenzione. La domanda di litio è in rapido aumento e non è sostenibile mantenere l’estrazione di nuove risorse di litio“, aggiunge.
Litio, cobalto e altri metalli presenti nella batterie sono molto rari e costosi da estrarre quindi oltre ad inquinare meno, il loro riciclaggio comporta anche una riduzione dei costi e un minore impatto sull’ambiente anche per una loro minore estrazione. Esistono già dei metodi per la separazione di tali metalli, ma richiedono alte temperature e prodotti chimici. La squadra di Cunningham sta sviluppando un sistema sicuro per l’ambiente grazie all’utilizzo di organismi presenti in natura, i funghi. I funghi sono economici e non inquinano, quindi hanno una doppia valenza nel riciclaggio delle batterie al litio.
Il processo utilizza tre ceppi di funghi: Aspergillus niger, Penicillium simplicissimum e Penicillium Chrysogenum. Questi ceppi sono stati già osservati nell’efficace estrazione di metalli da altri tipi di rifiuti. “Abbiamo pensato che i meccanismi di estrazione dovrebbero essere simili, e, se lo sono, questi funghi potrebbero lavorare per estrarre litio e cobalto dalle batterie esauste“, afferma Cunningham.
Il processo. La squadra prima smonta le batterie e polverizza i catodi. Poi, espongono ciò che rimane al fungo che produce acidi organici che lavorano per filtrare i metalli. Attraverso l’interazione del fungo, dell’acido e del catodo polverizzato, è possibile estrarre cobalto e litio. L’obiettivo è quello di recuperare quasi tutto il materiale presente nell’accumulatore.
I risultati dimostrano che, utilizzando acido ossalico e acido citrico, due degli acidi organici generati dai funghi, è possibile estrarre fino all’85 per cento del litio e fino al 48 per cento del cobalto. In questo processo il cobalto e il litio si trovano immersi nell’acido liquido e il prossimo obiettivo è quello di estrarre i due elementi dal liquido.


























